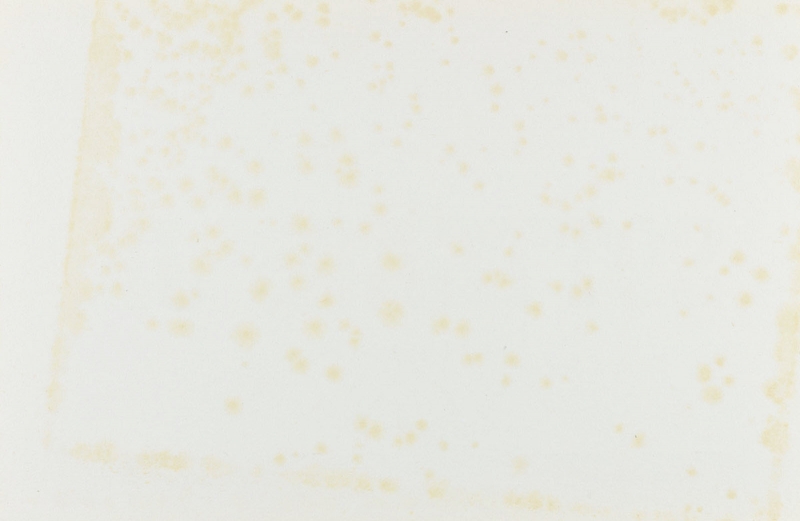
Immagine  -page002.jpg 1056

Le Mostre d´Arte Moderna nelle Gallerie private in Italia: i due decenni cruciali 1960 - 1980
Dipinti di Sottsass Jr.
Autore/i: Redazionale
Data: 1965
Descrizione fisica: 2 pp.; 12,5x17 cm
Note: L´invito è un cartoncino stampato su un solo lato
Collocazione: Collezione privata
Share